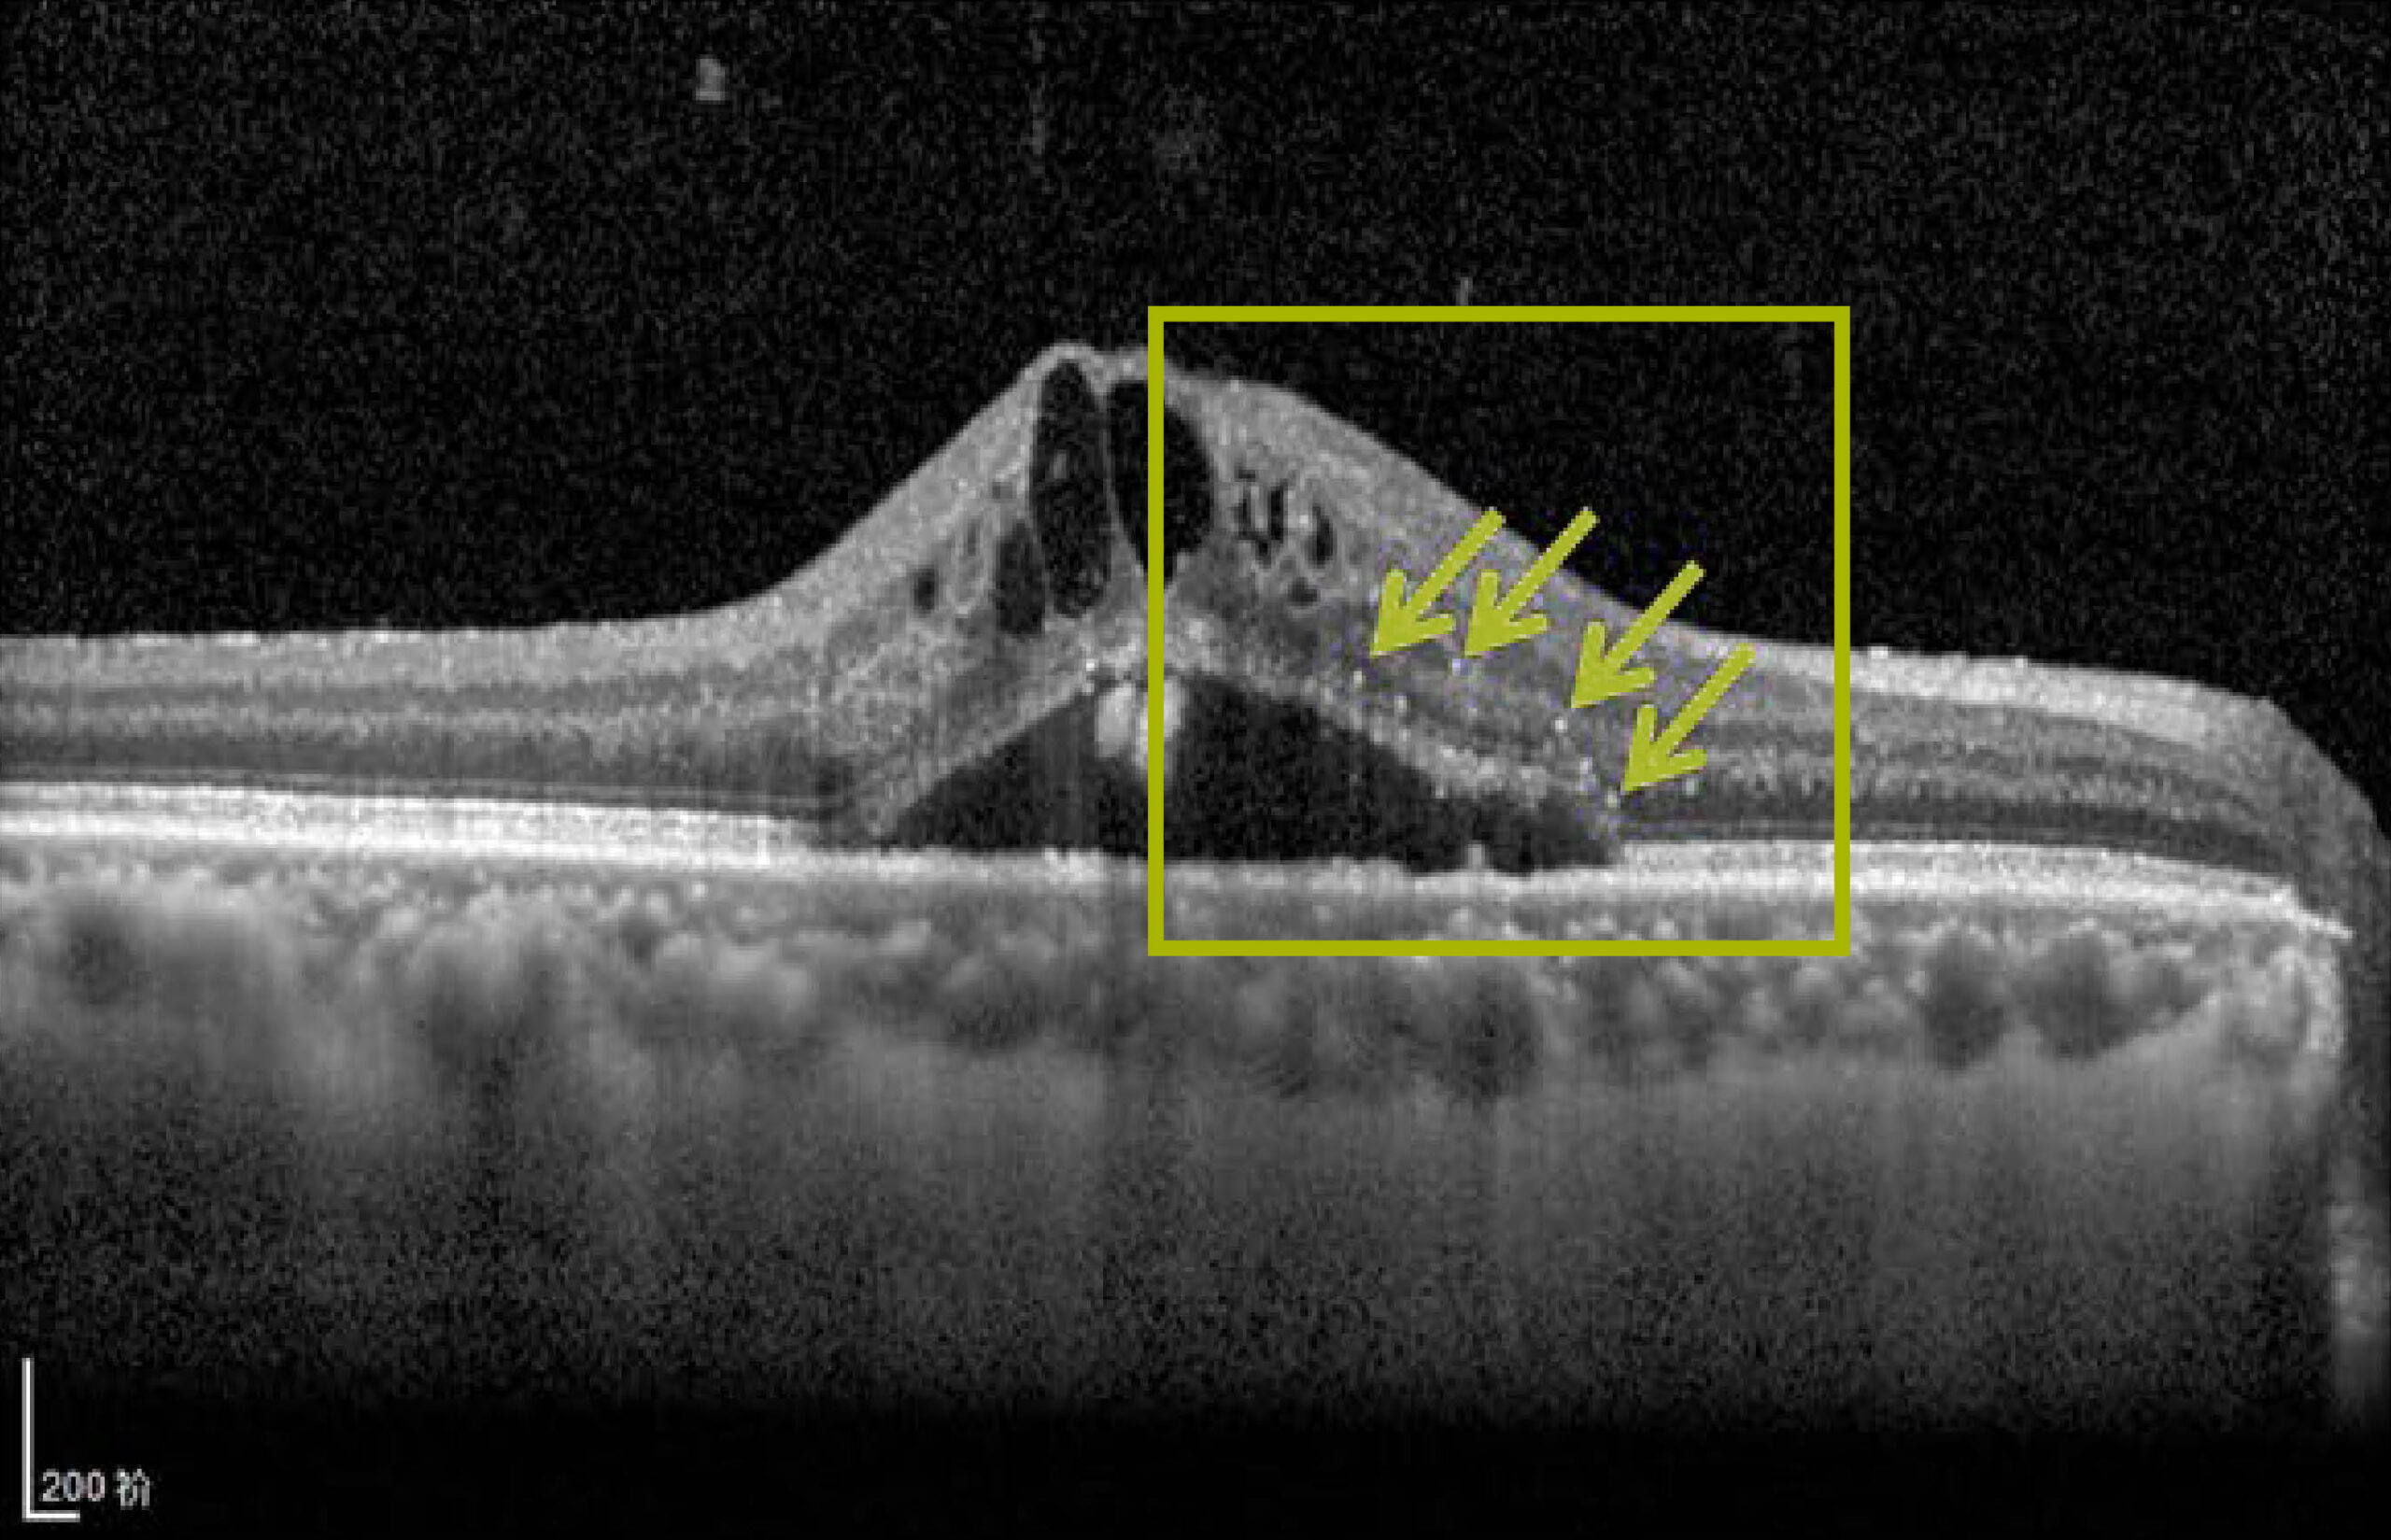

Hyperreflektive Foci: Was sind das für Punkte im OCT?
Sind auf den Bildern aus der optischen Kohärenztomographie (OCT) kleine weiße Punkte zu entdecken, können sie entscheidende Hinweise zur Krankheitsaktivität und Behandlung geben. Hyperreflektive Foci (HRF) gelten als Entzündungsmarker und scheinen ein wichtiger Prädiktor für ein gutes Ansprechen auf Steroide zu sein.1,2
Bild: Hyperreflektive Foci sind kleine, punktförmige Läsionen, die in den inneren und äußeren Netzhautschichten auftreten.2 Abbildung adaptiert nach Zhu B et al., 2017.20
Hyperreflektive Foci (HRF) sind kleine, gut abgegrenzte, punktförmige Läsionen mit einem Durchmesser von etwa 20–40 µm, die im OCT ähnlich oder stärker reflektieren als das retinale Pigmentepithel. HRF werden bei verschiedenen Retinaerkrankungen gefunden, sie spielen als Biomarker eine wichtige Rolle zur Prädiktion des diabetischen Makulaödems (DMÖ) und von Ödemen nach einem retinalen Venenverschluss (RVV). HRF können in inneren und äußeren Netzhautschichten lokalisiert werden, sie treten häufig in der Nähe von Mikroaneurysmen und intraretinalen Zysten auf. Auch in der Aderhaut können sie als Zeichen einer fortgeschrittenen Leckage zu finden sein.1
Was HRF darstellen, ist nicht genau geklärt. Beim DMÖ vermutet man, dass HRF lipidbeladene Makrophagen sind – was auf eine entzündliche Aktivität hinweist. Eine andere Erklärung bringt HRF mit aktivierten, residenten Mikrogliazellen in Verbindung. Fest steht: In ihrer Gegenwart ist nicht nur CD14, sondern auch die Konzentrationen von Interleukin-1β und Interleukin-6 erhöht – klare Hinweise auf eine verstärkte Entzündungsaktivität.1
Je mehr HRF, desto fortgeschrittener die diabetische Retinopathie
Die Anzahl der Foci gilt als Biomarker für die Erkrankungsschwere, und die Präsenz vieler HRF wurde in mehreren Studien mit schlechtem Ansprechen auf eine Anti-VEGF-Therapie in Verbindung gebracht.1,3,4
In einer Vergleichsstudie mit 156 therapienaiven DMÖ-Patient*innen wurde die therapeutische Wirksamkeit des Dexamethason-Implantats OZURDEX mit der intravitrealen Applikation von Ranibizumab verglichen und auch anhand von OCT-Biomarkern evaluiert. Bei der Reduktion der HRF zeigte sich das Kortikoid der Anti-VEGF-Therapie signifikant überlegen.5
Der prognostische und prädiktive Stellenwert von HRF beim DMÖ lässt sich in vergleichbarem Maß auf retinale Gefäßerkrankungen übertragen. Auch beim RVV weisen sie auf einen erhöhten Entzündungszustand hin und bedeuten eine ungünstige Prognose des Makulaödems. Eine Studie mit 139 behandlungsnaiven Patient*innen mit einem Makulaödem bei retinalem Venenastverschluss verglich die Wirkung von intravitrealem Bevacizumab** mit einem Dexamethason-Implantat. Es zeigte sich eine überlegene Reduktion der äußeren retinalen HRF unter Dexamethason.6
Zusammengefasst stellt sich die Präsenz von HRF zunehmend als ein wichtiger Biomarker für ein besseres Ansprechen auf Steroide im Vergleich zu Anti-VEGF-Behandlung heraus1,2 – mit hoher Relevanz für den Praxisalltag. Möglicherweise können KI-Tools zukünftig bei der Quantifizierung von HRF unterstützen, um so eine bessere Therapieentscheidung zu ermöglichen.
Das intravitreale Dexamethason-Implantat OZURDEX kann bei DMÖ und RVV als First-Line-Therapie eingesetzt werden# und zeichnet sich durch einen schnellen Wirkeintritt mit deutlichem Visusgewinn bereits nach einer Woche aus.7,8,9,10 Die Low-Response-Raten*** lagen in Studien dabei unter 20 %.11,12,13 Unter Anti-VEGF-Therapien wird in klinischen und Real-World-Studien ein Anteil von rund 30 bis 40 % Low-Respondern beim Visus-Gewinn berichtet.14,15,16 Das heißt, viele Patient*innen sprechen nicht mit ausreichendem Visusgewinn auf eine Anti-VEGF-Therapie an. Daher: OZURDEX von Anfang an.7,17,18,19
|